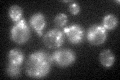
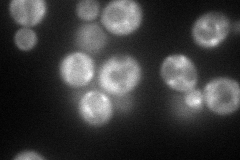
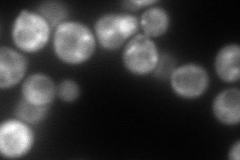
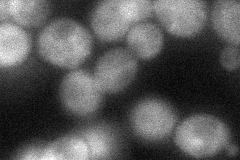
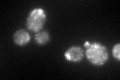

View description
Protein involved in the regulation of cell wall synthesis; proposed to be involved in coordinating cell cycle progression with cell wall integrity
Localization:
Intensity:
Fold change:
Significance:
-
C’ GFP library in SD
punctate50.84 -
N' NOP1pr-GFP in SD
cytosol,punctate110.334 -
N' TEF2pr-mCherry in SD
punctate156.921 -
N' NATIVEpr-GFP in SD

punctate75.4743 -
N' TEF2pr-VC and Cyto-VN in SD
cytosol46.8678 -
C’ GFP library in SD+DTT
punctate49.130.96No -
C’ GFP library in SD+H2O2

punctate63.071.24No -
C’ GFP library in Starvation Media

punctate22.050.43Yes -
C’ GFP library on the background of Pup2-DaMP

vacuole -
C’ GFP library on the background of CCT mutant

punctate61.67171.21298No
